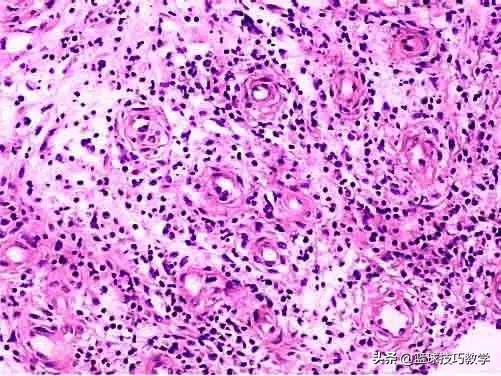
打球崴脚急救措施,打球崴脚了怎么高情商安慰

最近很多兄弟私信问我,打球受伤后怎么才能快速恢复,于是我请教了广州和平骨科医院运动康复中心的曾医生,下面我就来给兄弟们科普一下吧!
很多兄弟都有以下的经历吧:自从某次受伤后,跳得不如以前高,跑得没以前快,动作没以前利索。
这是伤病没恢复好,还是年纪大了导致跳不起来了?

也许,只是我们没有做好康复而已。(以踝关节内翻扭伤为例)
当我们受伤时,这4个过程我们要十分注意:
1. 紧急处理:损伤发生后的3分钟。
2. 治疗:损伤发生后的3天。
3. 康复:损伤发生后的3周。
4. 调整:损伤发生后的3个月。

第一点,紧急处理(共分为四点,简称STOP)
①S(stop,受伤后必须立刻停止运动)
②T(talk,了解关于受伤的问题)
③O(observe,观察有无肿胀、伤痕、变形和触痛的情况)
④P(prevent,切记防止发生进一步的损伤)


第二点,治疗(共分为五点,简称RICER)
①R(rest,休息)
②I(ice冰敷)
③C(compression 加压包扎)
④E(elevation 抬高患处)
⑤R(referral 方案)。

这里有几个点是需要我们注意的。
1、受伤了不能马上涂药物,这样容易引起伤口变大。
2、如果实在疼痛,可以采取冰敷的办法,譬如用保鲜袋装冰水混合物。如果早期冰敷没做好,会延长伤口修复时间。

3、教大家一个判断是否需要冰敷的方法,在球队里,专业的运动员会用手背贴在患处,感受是否发热, 如果有发热感就冰敷 ,如果无法判断是否发热,可以对比相邻部位。
(必须是手背,不能用手心,因为温觉感受器主要在手背侧)

第三点,康复期
(主要是瘢痕组织处理和主动身体素质恢复。这也是我国绝大部运动爱好者,甚至是职业运动员都没做好的地方,也是与国外在运动损伤处理上差距最大的地方)

在这里,也有两个重点:
1、什么是瘢痕组织?为什么他会使恢复效果大打折扣?
答:这是一种由胶原蛋白组成,其是一种非常脆弱、僵硬的纤维组织。通过这种组织可将两侧受伤的软组织连结在一起,以达到修复的目的。
新生的瘢痕组织绝不会与原有组织一样结实,甚至还可挤压周围正常的组织而使之变形。其结果不仅会使此处修复好的组织强度降低,还会使其柔韧度降低。
这就意味着软组织将会缩短,继而形成隐患,极易引起伤情加重或旧伤复发。再者,瘢痕组织的形成还可导致力量和爆发力下降。因为肌肉要获得最大力量,就需要在收缩前有充分的拉伸。如果可收缩组织缩短,肌肉便不可能进行充分拉伸和收缩。

同时,瘢痕组织内的血供情况比正常情况差,而血管对温度、湿度变化非常敏感,所以没处理好的瘢痕组织因为在天气转换时,引起局部组织一定的不适感,被我们称为“天文台”。
因此,早期一定要超声波、热疗、深层接摩等方法处理好瘢痕组织,以免引起日后的运动表现。

2、该如何主动恢复?
2020年,全国队医培训的主要思想之一:运动受的伤,在运动中恢复。主动恢复包括柔韧性、力量、爆发力、耐力、平衡和协调等五大身体素质的恢复。

我们要有计划地进行拉伸的力量训练,是恢复受伤部位的健康要素。
传统的思想是休息为主,休息可以避免损伤加重,但不能给予伤处恢复所需的充足血液。只有积极良好的血液循环才能保证受伤部位获得恢复所需的氧气和营养物质。
因此,在恢复到一定程度时,我们要适当的做些运动。

最后,在受伤后,我们必须找出受伤原因。例如:
意外事故:突然踩空、被撞倒等。
负荷过量:过硬的场地、长时间停止运动后突然运动、训练强度和持续时间增加的过快、运动鞋过于破旧或者不适合等。
生物力学:长短脚、扁平足、脊柱侧弯、肌肉僵硬或者乏力等。
注意以上这些问题,如果有,一定先要解决再参与运动,否则会出现容易出现更严重的损伤。良好的运动环境会提高我们的运动表现和降低运动风险。
